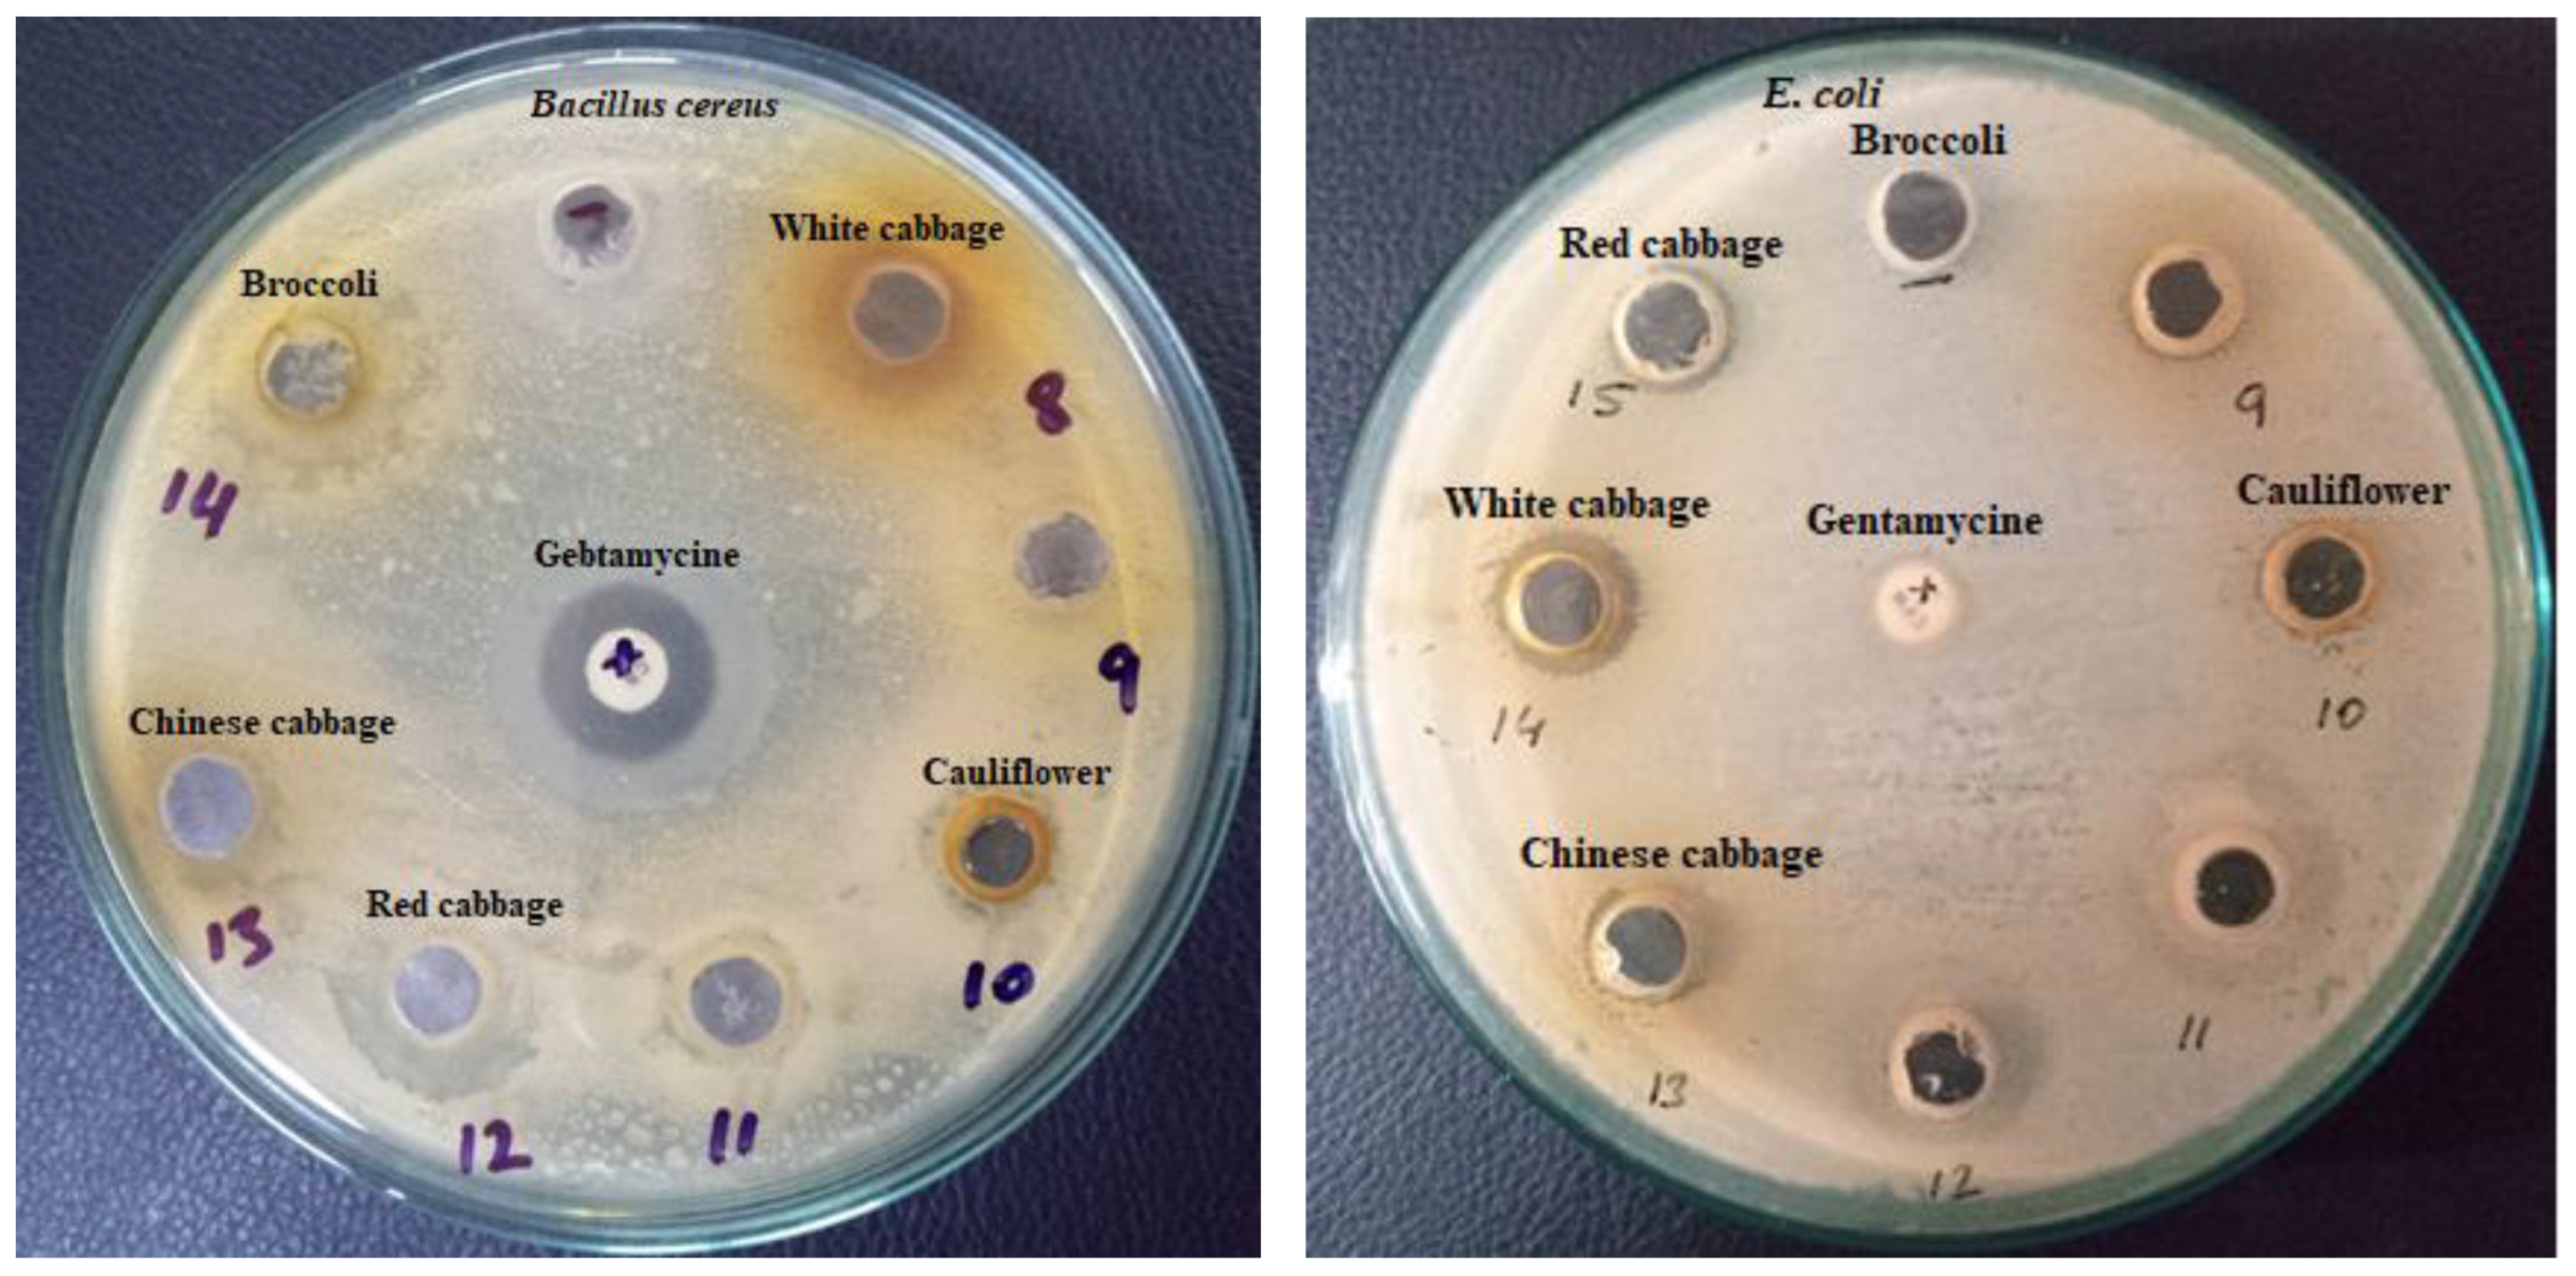
Applsci 12 05811 g003

Inter-Varietal Variation in Phenolic Profile, Sugar Contents, Antioxidant, Anti-Proliferative and Antibacterial Activities of Selected Brassica Species
Abstract
:1. Introduction
2. Materials and Methods
2.1. Collection and Pretreatment of Plant Materials
2.2. Extract Preparation
2.3. Quantification of Phenolic Acids and Flavonoids by HPLC
2.4. Quantification of Sugar Profile by HPLC
2.5. Evaluation of Total Phenolic Contents
2.6. Evaluation of Total Flavonoids Contents
2.7. Radical Scavenging Activity (DPPH)
2.8. Reducing Potential
2.9. Antibacterial Activities
2.10. Cell Culture
MTT Assay
2.11. Statistical Analysis
3. Results and Discussion
3.1. Extracts Yield (g/100 g)
3.2. Quantification of Phenolic acids and Flavonoids by HPLC
3.3. Quantification of Sugars by HPLC
3.4. Evaluation of Antioxidant Activities
3.4.1. Total Phenolics and Total Flavonoids Contents
3.4.2. Radical Scavenging Activity (DPPH)
3.4.3. Reducing Potential
3.5. Antibacterial Activity
3.6. Anti-Proliferative Activity of Extracts
4. Conclusions
Author Contributions
Funding
Institutional Review Board Statement
Informed Consent Statement
Data Availability Statement
Conflicts of Interest
References
- Vukasović, T. Functional foods in line with young consumers: Challenges in the marketplace in Slovenia. Dev. New Funct. Food Nutraceutical Prod. 2017, 2, 391–405. [Google Scholar]
- Lenssen, K.G.; Bast, A.; de Boer, A. Clarifying the health claim assessment procedure of EFSA will benefit functional food innovation. J. Funct. Foods 2018, 47, 386–396. [Google Scholar] [CrossRef]
- Mehari, B.; Chandravanishi, B.S.; Redi-Abshiro, M.; Combrinck, S.; McCrindle, R.; Atlabachew, M. Polyphenol contents of green coffee beans from different reagions of Ethiopia. Int. J. Food Prop. 2020, 24, 17–27. [Google Scholar] [CrossRef]
- Rad, A.H.; Maleki, L.A.; Kafil, H.S.; Zavoshti, H.F.; Abbasi, A. Postbiotics as novel health-promoting ingredients in functional foods. Health Promot. Perspect. 2020, 10, 3–4. [Google Scholar]
- Aneklaphakij, C.; Saigo, T.; Watanabe, M.; Naake, T.; Fernie, A.R.; Bunsupa, S.; Tohge, T. Diversity of Chemical Structures and Biosynthesis of Polyphenols in Nut-Bearing Species. Front. Plant Sci. 2021, 12, 440–448. [Google Scholar] [CrossRef]
- Poschner, S.; Maier-Salamon, A.; Thalhammer, T.; Jäger, W. Resveratrol and other dietary polyphenols are inhibitors of estrogen metabolism in human breast cancer cells. J. Steroid Biochem. Mol. Biol. 2019, 190, 11–18. [Google Scholar] [CrossRef]
- Poveda, J.; Francisco, M.; Cartea, M.E.; Velasco, P. Development of transgenic Brassica crops against biotic stresses caused by pathogens and arthropod pests. Plants 2020, 12, 1664. [Google Scholar] [CrossRef]
- Bassegio, D.; Zanotto, M.D. Growth, yield, and oil content of Brassica species under Brazilian tropical conditions. Bragantia 2020, 79, 203–212. [Google Scholar] [CrossRef]
- Bhandari, H.R.; Bhanu, A.N.; Srivastava, K.; Singh, M.N.; Shreya, H.A. Assessment of genetic diversity in crop plants-an overview. Adv. Plants Agric. Res. 2017, 7, 246–255. [Google Scholar]
- El-Esawi, M.A. Genetic diversity and evolution of Brassica genetic resources: From morphology to novel genomic technologies–a review. Plant Genet. Resour. 2017, 15, 388–399. [Google Scholar] [CrossRef]
- Granato, D.; Barba, F.J.; BursaćKovačević, D.; Lorenzo, J.M.; Cruz, A.G.; Putnik, P. Functional foods: Product development, technological trends, efficacy testing, and safety. Annu. Rev. Food Sci. Technol. 2020, 11, 93–118. [Google Scholar] [CrossRef] [PubMed] [Green Version]
- Šamec, D.; Pavlović, I.; Salopek-Sondi, B. White cabbage (Brassica oleracea var. capitata f. alba): Botanical, phytochemical and pharmacological overview. Phytochem. Rev. 2017, 16, 117–135. [Google Scholar] [CrossRef]
- Ramirez, D.; Abellán-Victorio, A.; Beretta, V.; Camargo, A.; Moreno, D.A. Functional ingredients from Brassicaceae species: Overview and perspectives. Int. J. Mol. Sci. 2020, 21, 1998. [Google Scholar] [CrossRef] [Green Version]
- Hussain, A.I.; Chatha, S.A.S.; Kamal, G.M.; Ali, M.A.; Hanif, M.A.; Lazhari, M.I. Chemical composition and biological activities of essential oil and extracts from Ocimum sanctum. Int. J. Food Prop. 2017, 20, 1569–1581. [Google Scholar] [CrossRef] [Green Version]
- Dominic, S.; Hussain, A.I.; Shahid Chatha, S.A.; Ali, Q.; Aslam, N.; Sarker, S.D.; Alyemeni, M.N. Phenolic Profile, Nutritional Composition, Functional Properties, and Antioxidant Activity of Newly Grown Parthenocarpic and Normal Seeded Tomato. J. Chem. 2021, 2021, 8826325. [Google Scholar] [CrossRef]
- Iftikhar, N.; Hussain, A.I.; Chatha, S.A.S.; Sultana, N.; Rathore, H.A. Effects of polyphenol-rich traditional herbal teas on obesity and oxidative stress in rats fed a high-fat–sugar diet. Food Sci. Nutr. 2022, 10, 698–711. [Google Scholar] [CrossRef] [PubMed]
- Djenidi, H.; Khennouf, S.; Bouaziz, A. Antioxidant activity and phenolic content of commonly consumed fruits and vegetables in Algeria. Prog. Nutr. 2020, 22, 224–235. [Google Scholar]
- Rasul, A.; Riaz, A.; Wei, W.; Sarfraz, I.; Hassan, M.; Li, J.; Li, X. Mangiferaindica Extracts as Novel PKM2 Inhibitors for Treatment of Triple Negative Breast Cancer. BioMed Res. Int. 2021, 2, 1349–1359. [Google Scholar]
- Podsedek, A.; Sosnowska, D.; Redzynia, M.; Anders, B. Antioxidant capacity and content of Brassica oleracea dietary antioxidants. Int. J. Food Sci. Technol. 2006, 41, 49–58. [Google Scholar] [CrossRef]
- Upadhyay, R.; Sehwag, S.; Singh, S.P. Antioxidant activity and polyphenol content of Brassica oleracea varieties. Int. J. Veg. Sci. 2016, 22, 353–363. [Google Scholar] [CrossRef]
- Bhandari, S.R.; Kwak, J.H. Chemical composition and antioxidant activity in different tissues of Brassica vegetables. Molecules 2015, 2, 1228–1243. [Google Scholar] [CrossRef] [PubMed] [Green Version]
- Rosa, E.; David, M.; Gomes, M.H. Glucose, fructose and sucrose content in broccoli, white cabbage and Portuguese cabbage grown in early and late seasons. J. Sci. Food Agric. 2001, 81, 1145–1149. [Google Scholar] [CrossRef]
- Sultana, B.; Anwar, F.; Przybylski, R. Antioxidant activity of phenolic components present in barks of Azadirachta indica, Terminalia arjuna, Acacia nilotica, and Eugenia jambolana Lam. trees. Food Chem. 2007, 104, 1106–1114. [Google Scholar] [CrossRef]
- Gaafar, A.A.; Aly, H.F.; Salama, Z.A.; Mahmoud, K.M. Characterizing the antioxidant and anticancer properties of secondary metabolites from red and white cabbages Brassica oleracea L. var. capitata. World J. Pharm. Res. 2014, 3, 171–186. [Google Scholar]
- Li, Z.; Lee, H.W.; Liang, X.; Liang, D.; Wang, Q.; Huang, D.; Ong, C.N. Profiling of phenolic compounds and antioxidant activity of 12 cruciferous vegetables. Molecules 2018, 23, 1139. [Google Scholar] [CrossRef] [Green Version]
- Sun, Y.P.; Chou, C.C.; Yu, R.C. Antioxidant activity of lactic-fermented Chinese cabbage. Food Chem. 2009, 11, 912–917. [Google Scholar] [CrossRef]
- Waghulde, S.; Khan, N.A.; Gorde, N.; Kale, M.; Naik, P.; Yewale, R.P. Comparative antimicrobial activity study of Brassica oleceracea. Multidiscip. Digit. Publ. Inst. Proc. 2018, 9, 64–76. [Google Scholar]
- Muntean, D.; Ştefănuţ, M.N.; Căta, A.; Buda, V.; Danciu, C.; Bănică, R.; Ienaşcu, I. Symmetrical Antioxidant and Antibacterial Properties of Four Romanian Cruciferous Extracts. Symmetry 2021, 5, 893. [Google Scholar] [CrossRef]
- Boivin, D.; Lamy, S.; Lord-Dufour, S.; Jackson, J.; Beaulieu, E.; Côté, M.; Béliveau, R. Antiproliferative and antioxidant activities of common vegetables: A comparative study. Food Chem. 2009, 112, 374–380. [Google Scholar] [CrossRef]
- Wang, N.; Wang, W.; Liu, C.; Jin, J.; Shao, B.; Shen, L. Inhibition of growth and induction of apoptosis in A549 cells by compounds from oxheart cabbage extract. J. Sci. Food Agric. 2016, 96, 3813–3820. [Google Scholar] [CrossRef]
- Brandi, G.; Schiavano, G.F.; Zaffaroni, N.; De Marco, C.; Paiardini, M.; Cervasi, B.; Magnani, M. Mechanisms of action and antiproliferative properties of Brassica oleracea juice in human breast cancer cell lines. J. Nutr. 2004, 135, 1503–1509. [Google Scholar] [CrossRef] [PubMed] [Green Version]

| Assays | Extracts | Butylated Hydroxytoluene (BHT) | ||||
|---|---|---|---|---|---|---|
| Cauliflower | Broccoli | Red Cabbage | White Cabbage | Chinese Cabbage | ||
| Yield (g/100 g) | 12.8 ± 0.64 a | 12.6 ± 0.63 a | 12.7 ± 0.63 a | 11.9 ± 0.58 a | 11.6 ± 0.59 a | --- |
| TPC (mg/g dry material) | 29.9 ± 1.7 c,d | 27.2 ± 1.6 c | 32.8 ± 1.9 d | 16.4 ± 0.9 b | 9.7 ± 0.6 a | --- |
| TFC (mg/g dry material) | 20.9 ± 1.2 c | 18.6 ± 1.1 c | 23.7 ± 1.1 d | 9.9 ± 0.6 b | 7.7 ± 0.4 a | --- |
| DPPH IC50 (µg/mL) | 3.1 ± 0.18 c | 3.4 ± 0.20 c | 2.3 ± 0.13 b | 3.7 ± 0.22 d | 4.6 ± 0.27 a | 1.5 ± 0.09 a |
| Compounds | mg/100 g of Dry Plant Material | ||||
|---|---|---|---|---|---|
| Cauliflower | Broccoli | Red Cabbage | White Cabbage | Chinese Cabbage | |
| Gallic acid | 18.35 ± 1.10 c | 4.80 ± 0.23 b | 113.21 ± 6.79 d | 4.90 ± 0.29 b | 3.00 ± 0.20 a |
| p-hydroxyl benzoic acid | 0.09 ± 0.02 b | 0.08 ± 0.05 b | 3.22 ± 0.19 d | 0.61 ± 0.01 c | 0.04 ± 0.01 a |
| Catechin | 2.94 ± 0.17 b | 0.53 ± 0.03 a | 151.8 ± 9.01 d | 2.93 ± 0.13 b | 3.44 ± 0.21 c |
| Chlorogenic acid | 0.55 ± 0.04 c | 0.44 ± 0.03 b | 25.7 ± 1.35 d | 0.41 ± 0.03 b | 0.09 ± 0.01 a |
| Caffeic acid | 0.02 ± 0.01 a | 0.03 ± 0.01 a | 1.11 ± 0.01 c | 1.01 ± 0.06 c | 0.07 ± 0.01 b |
| Syringic acid | 0.04 ± 0.01 a | - | _ | 0.14 ± 0.01 b | - |
| Vanillic acid | - | - | 0.51 ± 0.03 b | 0.02 ± 0.01 a | 0.03 ± 0.01 a |
| p-coumaric acid | 7.44 ± 0.45 b | - | 53.29 ± 3.73 c | 0.13 ± 0.01 a | - |
| Sinapic acid | 0.06 ± 0.01 b | 0.03 ± 0.01 a | 1.78 ± 0.10 c | - | 0.02 ± 0.00 a |
| Ferulic acid | 0.05 ± 0.01 a | - | 6.66 ± 0.45 b | - | 0.04 ± 0.01 a |
| Ellagic acid | - | - | 3.21 ± 0.20 a | - | - |
| Benzoic acid | 0.05 ± 0.01 a | - | 27.21 ± 1.06 b | - | - |
| Quercetin | 4.11 ± 0.30 a | - | 11.92 ± 0.72 b | - | - |
| Compounds | % Composition | ||||
|---|---|---|---|---|---|
| Cauliflower | Broccoli | Red Cabbage | White Cabbage | Chinese Cabbage | |
| Maltodextrose | 83.31 ± 4.99 c,d | 77.45 ± 4.65 c | 86.73 ± 5.21 d | 52.52 ± 3.15 a | 66.81 ± 4.01 b |
| Maltose | 2.32 ± 0.14 c | 1.48 ± 0.08 a | 2.03 ± 0.12 b | 4.90 ± 0.29 d | 1.74 ± 0.11 a |
| Glucose | 2.89 ± 0.17 a | 4.71 ± 0.28 b | 4.91 ± 0.29 b | 11.99 ± 0.72 d | 9.02 ± 0.54 c |
| Fructose | 11.47 ± 0.68 b | 14.47 ± 0.87 c | 5.32 ± 0.32 a | 28.64 ± 1.72 e | 22.45 ± 1.35 d |
| Extracts | Inhibition Zone (mm) | |
|---|---|---|
| Bacillus cereus | Escherichiacoli | |
| Cauliflower | 15.0 ± 0.55 c | 6.0 ± 0.31 a |
| Broccoli | 14.4 ± 0.51 c | <6 ± 0.21 a |
| Red Cabbage | 16.3 ± 0.71 c,d | 12.3 ± 0.42 c |
| White Cabbage | 10.5 ± 0.22 b | 14.4 ± 0.55 d |
| Chinese Cabbage | 8.23 ± 0.31 a | 12.7 ± 0.41 c |
| Gentamicin | 18.1 ± 0.91 d | 9.21 ± 0.25 b |
| Extracts | % Inhibition (40 mg/mL) |
|---|---|
| Cauliflower | 54.12 ± 3.3 b,c |
| Broccoli | 53.16 ± 2.3 b,c |
| Red Cabbage | 58.19 ± 1.6 c |
| White Cabbage | 51.93 ± 2.9 b |
| Chinese Cabbage | 30.3 ± 1.6 a |
Publisher’s Note: MDPI stays neutral with regard to jurisdictional claims in published maps and institutional affiliations. |
© 2022 by the authors. Licensee MDPI, Basel, Switzerland. This article is an open access article distributed under the terms and conditions of the Creative Commons Attribution (CC BY) license (https://creativecommons.org/licenses/by/4.0/).
Share and Cite
Zafar, I.; Hussain, A.I.; Fatima, T.; Abdullah Alnasser, S.M.; Ahmad, A. Inter-Varietal Variation in Phenolic Profile, Sugar Contents, Antioxidant, Anti-Proliferative and Antibacterial Activities of Selected Brassica Species. Appl. Sci. 2022, 12, 5811. https://doi.org/10.3390/app12125811
Zafar I, Hussain AI, Fatima T, Abdullah Alnasser SM, Ahmad A. Inter-Varietal Variation in Phenolic Profile, Sugar Contents, Antioxidant, Anti-Proliferative and Antibacterial Activities of Selected Brassica Species. Applied Sciences. 2022; 12(12):5811. https://doi.org/10.3390/app12125811
Chicago/Turabian StyleZafar, Irsa, Abdullah Ijaz Hussain, Tabinda Fatima, Sulaiman Mohammed Abdullah Alnasser, and Ashfaq Ahmad. 2022. "Inter-Varietal Variation in Phenolic Profile, Sugar Contents, Antioxidant, Anti-Proliferative and Antibacterial Activities of Selected Brassica Species" Applied Sciences 12, no. 12: 5811. https://doi.org/10.3390/app12125811
APA StyleZafar, I., Hussain, A. I., Fatima, T., Abdullah Alnasser, S. M., & Ahmad, A. (2022). Inter-Varietal Variation in Phenolic Profile, Sugar Contents, Antioxidant, Anti-Proliferative and Antibacterial Activities of Selected Brassica Species. Applied Sciences, 12(12), 5811. https://doi.org/10.3390/app12125811

